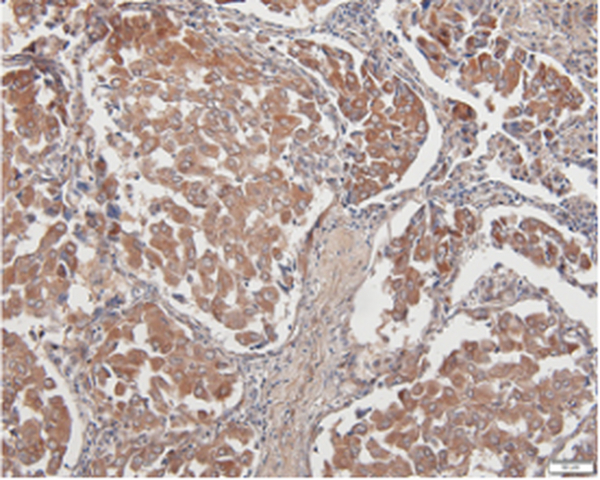
Anti PDL1 mouse monoclonal antibody

QQ:3002763590


客服电话:021-61998208
最新动态
-

α-tubulin mouse Monoclonal Antibody
2021-01-08 -

α-tubulin mouse Monoclonal Antibody(8F11)
2021-01-08
热门标签
- Histone H3 rabbit Polyclonal Antibody Histone H3抗体
- EGFR rabbit Polyclonal Antibody EGFR抗体
- Cy3 Conjugated
- AbFluor™ 555 Conjugated
- AbFluor™ 680 Conjugated
- AbFluor™ 350 Conjugated
- AbFluor™ 647 Conjugated
- AbFluor™ 594 Conjugated
- AbFluor™ 405 Conjugated
- Cy5 Conjugated
- AbFluor™ 488 Conjugated
- Cyclophilin B抗体 Cyclophilin B Monoclonal Antibody(2B10)
- COX IV抗体 COX IV Monoclonal Antibody(6C8)
- PCNA抗体 PCNA Monoclonal Antibody(12D10)
- FAK rabbit Polyclonal Antibody FAK抗体
邮箱:3002763590@qq.com
电话:021-61998208

扫码关注微信公众号